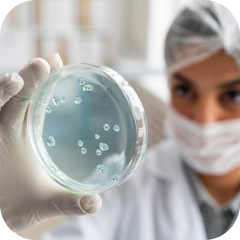
Тропическая медицина

Домашняя страница
Специальности
Эксперты всех медицинских специализаций в одном месте
Абдоминальная радиология -это раздел радиологии, который использует различные методы визуализации органов брюшной полости и таза с диагностической и лечебной целью.

Абдоминальная хирургия включает в себя диагностику и оперативные вмешательства в брюшной полости

Акушерство занимается наблюдением за беременностью и лечением матери и ребенка до, во время и после родов

Аллергология - это отрасль медицины, которая занимается изучением аллергии, ее развитием, проявлением, течением и лечением

Ангиология - это раздел внутренней медицины, изучающий функции и заболевания артерий, вен и лимфатических сосудов

Андрология - медицинская специальность, изучающая пороки развития, заболевания и травмы мужских половых органов.

Бариатрическая хирургия предусматривает хирургические вмешательства, направленные на снижение показателей лишнего веса

Венерология - отрасль медицины, занимающаяся диагностикой и лечением венерических заболеваний.

Эта область медицины специализируется на хирургическом лечении заболеваний, расположенных в брюшной полости

Гастроэнтерология занимается диагностикой и лечением заболеваний желудочно-кишечного тракта.

Гемостазиология оказывает помощь при заболеваниях и проблемах, связанных со свертываемостью крови

Генетика человека - это изучение наследственности и закономерностей генов, помогающая диагностировать врожденные генетические заболевания.
Операции на печени, желчных протоках и желудочно-кишечном тракте
Гериатрическая онкология изучает доброкачественные и злокачественные новообразования, возникающие у людей в пожилом возрасте
Гипертензиология занимается изучением причин и лечением высокого кровяного давления.
Глазная онкология – медицинская специальность, занимающаяся различными видами диагностики и лечения опухолей глаза

Задача этой отрасли медицины - лечение заболеваний, связанных с кожей, волосами, ногтями, а также решение некоторых косметических проблем

Детская онкология и гематология - это специальность педиатрии, занимающаяся диагностикой и лечением онкологических заболеваний и болезней крови

Эта медицинская область занимается оценкой и лечением расстройств мозга детей и подростков, которые проявляются в их действиях и поведении

Педиатрическая кардиология занимается лечением врожденных и приобретенных заболеваний сердца и кровеносной системы у детей.

Детская хирургия – это раздел хирургии, который занимается вопросами диагностики и лечения заболеваний и травм, врожденных патологий и пороков развития у детей.

Диабетология - отрасль медицины, занимающаяся профилактикой, диагностикой, терапией и исследованием сахарного диабета

Это отрасль медицины, которая охватывает широкий спектр заболеваний, поражающих внутренние органы организма.

Имплантология – это область стоматологии, направленная на восстановление зубного корня методом вживления в кость импланта в качестве опоры под протез

Интервенционная кардиология – это раздел кардиологии, который занимается катетерным лечением структурных заболеваний сердца
В интервенционной радиологии выполняются минимально инвазивные процедуры с использованием передовых методов визуализации.

Кардиовизуализация (также известная как сердечно-сосудистая визуализация) включает в себя различные методы получения изображений сердца
Этот раздел радиологии применяет современные технологии для визуализации органов грудной клетки, чтобы точно поставить диагноз и определить дальнейшее лечение.

Кардиоторакальная хирургия - это медицинская область, специализирующаяся на операциях в области груди, включая сердце, легкие и другие органы грудной клетки.

Диетология - это междисциплинарная медицинская дисциплина, которая использует научные данные о питании человека для профилактики, лечения и уменьшения болезней.
Ларингология - это раздел оториноларингологии, который занимается изучением строения, функций, заболеваний и методов лечения гортани

Это направление занимается уходом и лечением нарушений метаболизма и проблем с получением энергии

Операции MIS проводятся с минимальной травмой кожи и мягких тканей и сопровождаются меньшим количеством осложнений.

Неврология занимается заболеваниями нервной системы, включая головной и спинной мозг, а также периферические нервы.
Нейроонкология специализируется на опухолях центральной и периферической нервной системы.

Нейроортопедия изучает диагностику и лечение ортопедических заболеваний нервной системы
Нейроофтальмология — медицинская специальность, занимающаяся лечением заболеваний глаз и нервной системы, а также головных болей, вызванных глазными заболеваниями

Нейрохирургия занимается оперативным лечением заболеваний головного, спинного мозга и периферической нервной системы.

Нефрология - область медицины, занимающаяся диагностикой, лечением и профилактикой заболеваний почек.

Общая медицина - это медицинская отрасль, занимающаяся диагностикой, лечением и профилактикой широкого спектра заболеваний и отклонений в работе организма.

Общая стоматология занимается профилактикой, выявлением и лечением заболеваний, поражающих зубы, челюсти и полость рта.

Общая хирургия - это обширная область хирургии, в рамках которой выполняются различные хирургические вмешательства, в том числе и операции на брюшной полости
Онкогинекология — это раздел медицины, который занимается лечением опухолей женских репродуктивных органов
Онкодерматология - это раздел медицины, который диагностирует и лечит доброкачественные и злокачественные новообразования кожи

Онкология — это область медицины, посвященная изучению, диагностике и лечению злокачественных новообразований (рака).

Онкологическая хирургия - это хирургическая специальность, занимающаяся операциями по удалению опухолей и раковых тканей

Оптометрия - это раздел офтальмологии, занимающийся исследованием глаз и связанных с ними структур на предмет выявления дефектов и отклонений.

Ортопедическая хирургия занимается лечением заболеваний и травм опорно-двигательного аппарата.

Она относится к единой общей специальности - отоларингологии, изучающей заболевания уха, горла и носа

Офтальмология — это раздел медицины, который занимается лечением, диагностикой и профилактикой глазных заболеваний.

Пародонтология - это стоматологическая специальность, которая занимается изучением опорных структур зубов, а также заболеваний и состояний, которые на них влияют.

Педиатрия - это медицинская область, специализирующаяся на здоровье детей и подростков. Она включает в себя диагностику, лечение и профилактику заболеваний.

Эта область медицины включает в себя лечение и первичную помощь детям и подросткам

Пластическая хирургия позволяет устранить дефекты лица и тела, которые могут быть как врожденными, так и результатом травм, ожогов или болезней

Медицинская дисциплина, которая занимается изучением, лечением и профилактикой заболеваний толстого кишечника и анального канала

Психиатрия - медицинская специальность, занимающаяся диагностикой, профилактикой и лечением патологических психических состояний

Радиология — раздел медицины, изучающий использование рентгена, КТ, МРТ, УЗИ и ПЭТ для диагностики и лечения заболеваний.
Этот раздел радиологии применяет методы визуализации для диагностики заболеваний органов в области головы, шеи и центральной и периферической нервной системы.
Эта область радиологии использует методы визуализации для диагностики различных состояний и заболеваний органов мочеполовой системы.

Радиационная онкология-область медицины, которая использует ионизирующее излучение для уничтожения раковых клеток и лечения злокачественных опухолей.

Комплексное медицинское направление представляет собой сочетание лучевой терапии и медицинской онкологии для лечения рака.

Ревматология - отрасль медицины, специализирующаяся на системных аутоиммунных заболеваниях, поражающих многие органы организма.

Сердечно-сосудистая хирургия занимаетс диагностикой, лечением и устранением заболеваний сердца и кровеносных сосудов
Скелетно-мышечная радиология занимается визуализацией костей, мышц, суставов, сухожилий и связок для диагностики различных травм и заболеваний.

Сосудистая хирургия - отрасль хирургии, занимающаяся диагностикой и лечением заболеваний сосудистой системы.

Спортивная медицина занимается диагностикой и лечением спортивных травм путем восстановления соответствующих функций.

Спортивная ортопедия оказывает помощь спортсменам, получившим травмы или просто имеющим проблемы со здоровьем

Торакальная хирургия занимается диагностикой, лечением и восстановлением заболеваний органов грудной клетки, таких как легкие, сердце и пищевод.

Травматология - это специальность хирургии, которая занимается лечением травм и последствий несчастных случаев с повреждением опорно-двигательного аппарата.
Тропическая медицина - область медицины, занимающаяся контролем, профилактикой и эпидемиологией заболеваний, возникающих в тропическом и субтропическом климате.
УЗИ сосудов позволяет без лучевой нагрузки изучить состояние сосудов и оценить характер кровотока в них.

Урологическая онкология - одно из основных направлений урологии, занимающееся диагностикой и лечением опухолей всего мочеполового тракта